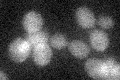
YPL196W
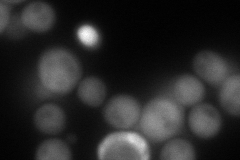
YPL196W
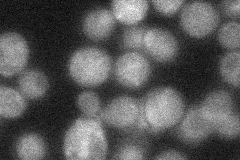
YPL196W

View description
Protein of unknown function required for normal levels of resistance to oxidative damage, null mutants are sensitive to hydrogen peroxide; member of a conserved family of proteins found in eukaryotes but not in prokaryotes
Localization:
Intensity:
Fold change:
Significance:
-
C’ GFP library in SD
below threshold16.05 -
N' NOP1pr-GFP in SD

cytosol0 -
N' TEF2pr-mCherry in SD
cytosol126.27 -
N' NATIVEpr-GFP in SD
cytosol24.6372 -
N' TEF2pr-VC and Cyto-VN in SD

#N/A0 -
C’ GFP library in SD+DTT

cytosol13.940.86No -
C’ GFP library in SD+H2O2

cytosol15.530.96No -
C’ GFP library in Starvation Media

cytosol17.31.07No -
C’ GFP library on the background of Pup2-DaMP

N/A -
C’ GFP library on the background of CCT mutant

N/A0N/AYes
